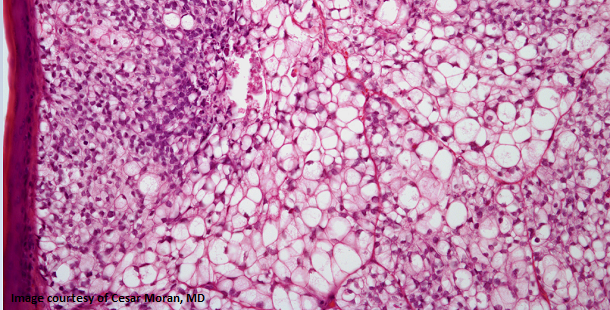

Right Arm Skin Lesion Found in 54-Year-Old Woman
A 54-year-old woman is found to have a skin lesion in the right arm. What is your diagnosis?
A 54-year-old woman is found to have a skin lesion in the right arm. Looking at the skin biopsy slide image below, what is your diagnosis?
.PNG?fit=crop&auto=format)
What is your diagnosis?